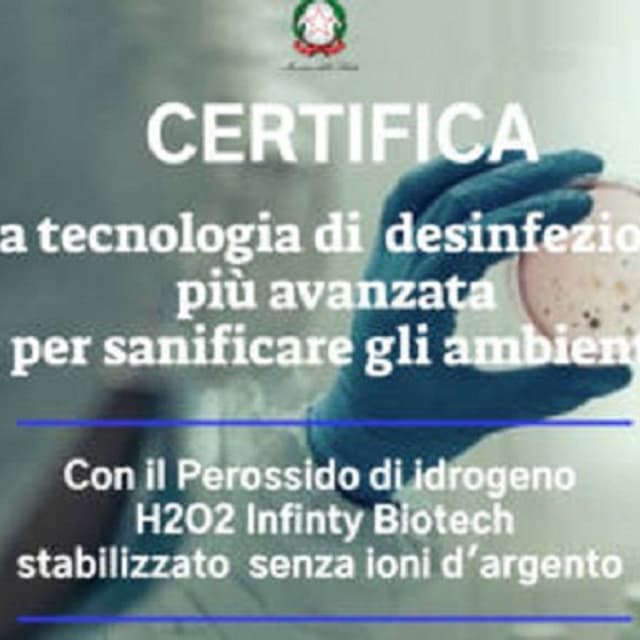
Tekno Disinfest - Immagine 1

Tekno Disinfest
Acquista online
Gestisci la tua attività su MapTap.it
Reclama Tekno Disinfest per accedere al pannello di gestione, rispondere alle recensioni e aggiornare le informazioni del tuo business
Descrizione
Galleria


Perché non sono visibili?
Questa attività è su un Piano Gratuito. Passa a un piano Premium per sbloccare tutti i servizi.
È la tua attività?
Servizi offerti
Perché non sono visibili?
Questa attività è su un Piano Gratuito. Passa a un piano Premium per sbloccare tutti i servizi.
È la tua attività?
Informazioni legali
Domande frequenti
Dove si trova Tekno Disinfest?
Tekno Disinfest si trova in Via Federico Tesei, 26, 62010 Casette Verdini, Macerata.
Quali sono gli orari di apertura di Tekno Disinfest?
Gli orari di apertura di Tekno Disinfest non sono attualmente disponibili.
Come posso contattare Tekno Disinfest?
Puoi contattare Tekno Disinfest al telefono +39 338 1185940 o via email a teknodisinfest@gmail.com.
Come raggiungere Tekno Disinfest?
Tekno Disinfest si trova in Via Federico Tesei, 26, 62010 Casette Verdini, Macerata. Puoi utilizzare Google Maps o Apple Maps per ottenere indicazioni stradali.
Quali servizi offre Tekno Disinfest?
Tekno Disinfest offre i seguenti servizi: Disinfezione uffici, Sanificazione ambientale, Preventivi gratuiti, Disinfezione enti pubblici, Disinfestazione ecologica, Disinfestazione negozi, Nebulizzazione, Pronto intervento.
Sei il proprietario?
Reclama questa attività per gestire il tuo profilo e ricevere recensioni
Informazioni rapide
Attività simili nelle vicinanze
Deco edil
Disinfestazioni Derattizzazioni Stopper
La Stopper è un'azienda con certificazione HACCP che opera nel settore della sanificazione ambientale ed effettua disinfestazioni, derattizzazioni, bonifiche ed irrigazioni, da oggi specializzata nella sanificazione e disinfezione ambienti da CORONAVIRUS - COVID 19. Siamo specializzati nella disinfestazione di aziende e uffici, ma operiamo anche in ristoranti, negozi, abitazioni private, parchi e condomini. Trattiamo prodotti topicidi e disinfestanti ed effettuiamo trattamenti antiparassitari e servizi di disinfestazione da mosche, zanzare, vespe e calabroni, acari, zecche, pidocchi, pulci, formiche, scarafaggi, cimici, tarli, rettili e ragni, topi e ratti con consulto e preventivo gratuiti. Offriamo un affidabile ed efficiente servizio di pronto intervento.
Folgore di Paolini Massimo
Folgore è un'azienda qualificata che opera nel campo della disinfestazione e dell'igiene ambientale. Due settori di notevole importanza per la salvaguardia della salute, dell'ambiente, dell'igiene, della sicurezza alimentare e per la protezione dei nostri beni. L'azienda di Massimo Paolini, tecnico della disinfestazione con oltre 15 anni di esperienza nel settore pubblico ha costituito una base solida che ha portato Folgore a essere una delle più qualificate imprese di disinfestazione della provincia di Macerata. Il continuo aggiornamento del personale, l'impiego di prodotti e attrezzature idonee e all'avanguardia e la membership con A.N.I.D. (Associazione Nazionale delle Imprese di Disinfestazione), rendono Folgore un partner qualificato e affidabile nel campo dell'igiene ambientale. Folgore effettua servizi e consulenze riguardanti: disinfestazione e derattizzazione, allontanamento volatili e disinfezione. La ditta esegue redazione piani HACCP e mette in atto procedure di difesa del verde ornamentale.
Neo Dis
La Neo Dis a Fermo, si occupa in maniera professionale di sterilizzazione sanitaria e disinfestazione contro parassiti degli alimenti, insetti striscianti e alati, derattizzazione, evacuazione volatili e manutenzione aree verdi. Ci occupiamo di eliminarne la presenza all’ interno di edifici, uffici e appartamenti di insetti, scarafaggi o parassiti per migliorare la sanità dell’essere umano, prevenire disagi, malattie o infezioni.
Sani Green Disinfestazione Multiservice
La nostra azienda offre soluzioni professionali per la gestione e il controllo degli infestanti, con l’obiettivo di garantire ambienti sani, sicuri e protetti. Grazie a un team esperto e a metodi certificati, interveniamo in modo rapido ed efficace in contesti residenziali, commerciali e industriali, assicurando sempre il massimo rispetto per la salute delle persone, degli animali e dell’ambiente.Ci occupiamo di disinfestazione e prevenzione, eliminando insetti fastidiosi e dannosi con tecniche avanzate che preservano la sicurezza degli spazi. Operiamo nella derattizzazione per prevenire e debellare infestazioni di roditori, proteggendo strutture, merci e persone da rischi sanitari e danni materiali.Siamo inoltre specializzati nell’allontanamento volatili, con soluzioni mirate e non invasive che impediscono agli uccelli infestanti di compromettere igiene e strutture, evitando problemi a impianti e superfici. Parallelamente, offriamo servizi professionali di pulizia completi per edifici residenziali, commerciali e industriali, garantendo ordine, igiene e decoro in ogni ambiente.La nostra esperienza si estende anche al settore marittimo e portuale, dove interveniamo per eliminare parassiti e insetti da merci e imbarcazioni, preservando l’integrità dei beni e la sicurezza delle operazioni. Inoltre, proteggiamo il legno da infestazioni di insetti xilofagi, muffe e danni ambientali, mantenendone intatta la qualità e prolungandone la durata nel tempo.Il nostro impegno quotidiano è fornire interventi tempestivi, soluzioni personalizzate e un servizio di qualità che duri nel tempo, offrendo ai nostri clienti la certezza di ambienti protetti, sicuri e impeccabilmente puliti in ogni circostanza.
Ulisse
Ulisse di Falconara Marittima fornisce sia a privati che ad aziende servizi di pulizia per ogni esigenza, garantendo alta qualità e professionalità! Siamo esperti nel campo delle pulizie civili e vi garantiamo un servizio accurato e professionale nella pulizia di alberghi, scuole, abitazioni e ospedali.? Laddove necessario interveniamo con una vera e propria disinfestazione da topi o, per meglio dire, derattizzazione. Grazie a moderne tecniche di controllo ed alla propria formazione professionale vi propone installazione di esche rodenticide che è uno dei metodi più efficaci per la buona riuscita della derattizzazione, permettono di intervenire rapidamente riducendo altrettanto velocemente la popolazione di topi e ratti infestanti. Tuttavia non può essere considerata una soluzione definitiva all’infestazione.Per maggior informazioni seguite la pagina Facebook "ULISSE S.R.L"